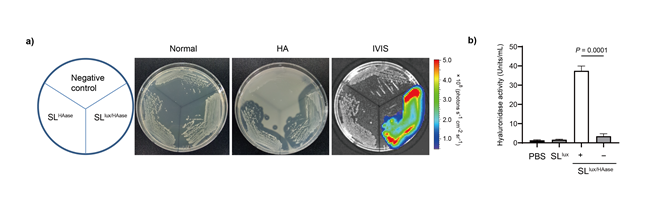

암 탐지와 표적 치료까지 가능한 항암 생균치료제 개발
암 탐지와 표적 치료까지 가능한 항암 생균치료제 개발
- 종양 세포외 기질 분해 효소를 함유한 약독화 살모넬라균 개발…암 표적화 후 항암물질을 종양 내부까지 침투시켜 항암치료의 효과 향상
- 암 탐지와 표적 치료까지 가능한 마이크로바이옴 기반 박테리아 생균을 이용한 항암치료제 개발 기여 기대
□ 국내 연구진이 기존 항암치료의 부작용과 한계를 대폭 개선한 표적 항암 생균 치료제를 개발하였습니다.
□ 한국생명공학연구원(원장 김장성, 이하 생명연) Open Access@KRIBB: Research Centers
생물자원센터 박승환 박사 연구팀은 종양 세포외 기질 분해 효소를 함유하여 암 종양 조직에 약물 침투성을 높여 항암치료의 효과와 효율성이 모두 향상된 항암 생균 치료제 개발에 성공하였다고 밝혔습니다.
ㅇ 향후 이를 활용한 마이크로바이옴 기반의 표적 항암치료제 개발에 기여할 수 있을 것으로 기대되고 있습니다.
□ 항암치료에 흔히 이용하는 약물치료나 방사선치료는 암세포뿐만 아니라 정상 세포에도 손상을 주거나, 과도한 사이토카인의 분비를 일으킨다는 단점이 있습니다.
ㅇ 이런 단점을 극복하기 위해 정상 세포에는 독성을 일으키지 않는 치료법이 연구되고 있으며, 그중 하나가 암을 표적 치료할 수 있는 박테리아를 이용한 항암 치료법입니다.
ㅇ 약독화(弱毒化) 살모넬라균은 암 조직에 강한 친화성을 가지고 있으며, 정상조직보다 암 조직에서 약 10만 배 정도 더 많이 증식한다고 알려져, 원하는 암세포를 표적화할 수 있고 독성을 약화한 박테리아에 항암물질을 함유시켜 전달하는 연구가 폭넓게 진행되고 있습니다.
□ 그러나 약독화 박테리아가 암을 탐지하여 표적화함에도 불구하고 박테리아에 함유된 항암물질이 암 종양을 둘러싸고 있는 종양 세포외 기질을 통과하지 못해 항암치료의 효율성이 낮다는 단점과 함께 항암제 투여 시 암세포 간 압력에 의해 항암제가 종양 안쪽까지 전달되지 못한다는 한계가 있습니다.
□ 이에 연구팀은 종양 세포외 기질을 분해할 수 있는 효소를 함유한 약독화 살모넬라균을 개발하였습니다.
ㅇ 박테리아가 암을 표적화하면 종양 세포외 기질의 주요성분인 히알루론산을 분해할 수 있는 히알루로니다아제 효소를 종양세포에 분비하여 세포외 기질의 경계를 허물어 약물 침투성이 높아져 항암물질이 종양 내부까지 침투할 수 있어 항암치료의 효과를 높일 수 있다는 것입니다.
ㅇ 연구팀은 췌장암과 유방암에 걸린 마우스 동물모델 실험을 통해 개발한 살모넬라균이 암세포의 성장 억제와 사멸이 진행되었으며 면역반응이 나타남을 확인하였습니다.
□ 연구책임자인 박승환 박사는 “암 탐지 및 표적 박테리아에 종양 세포외 기질 분해 효소를 발현시켜 종양 조직의 와해를 유도함으로써 지금까지 한계로 꼽혀온 종양 조직 약물 침투성과 방사선 치료침투 한도 등을 극복해 항암 복합치료제로서의 사용 가능성이 기대된다.”라며,
ㅇ “이번 연구를 통해 개발된 엔지니어링 박테리아는 효과적인 암 탐지 및 표적, 항암물질과 같은 다양한 치료물질의 효율적인 전달체로 항암치료 효과를 증대시킬 것이며, 이번 연구를 기반으로 한국인 마이크로바이옴 뱅크에서 우수한 항암 표적 박테리아를 발굴하여 마이크로바이옴 기반 항암 생균치료제 개발에 기여하겠다.”라고 밝혔습니다.
□ 한편 이번 연구는 약물전달시스템 분야의 세계적인 저널인 Journal of Controlled Release(IF 11.467) 3월호의 표지 논문으로 선정되었으며,
(논문명 : ECM-targeting bacteria enhance chemotherapeutic drug efficacy by lowering IFP in tumor mouse models/ 교신저자 : 박승환 박사 / 제1저자 : 김지선 박사)
ㅇ 과기정통부 바이오‧의료기술개발사업, 생명연 주요사업, 산업부 산업핵심기술개발 사업의 지원으로 수행되었습니다.
ㅇ 향후 이를 활용한 마이크로바이옴 기반의 표적 항암치료제 개발에 기여할 수 있을 것으로 기대되고 있습니다.
□ 항암치료에 흔히 이용하는 약물치료나 방사선치료는 암세포뿐만 아니라 정상 세포에도 손상을 주거나, 과도한 사이토카인의 분비를 일으킨다는 단점이 있습니다.
ㅇ 이런 단점을 극복하기 위해 정상 세포에는 독성을 일으키지 않는 치료법이 연구되고 있으며, 그중 하나가 암을 표적 치료할 수 있는 박테리아를 이용한 항암 치료법입니다.
ㅇ 약독화(弱毒化) 살모넬라균은 암 조직에 강한 친화성을 가지고 있으며, 정상조직보다 암 조직에서 약 10만 배 정도 더 많이 증식한다고 알려져, 원하는 암세포를 표적화할 수 있고 독성을 약화한 박테리아에 항암물질을 함유시켜 전달하는 연구가 폭넓게 진행되고 있습니다.
□ 그러나 약독화 박테리아가 암을 탐지하여 표적화함에도 불구하고 박테리아에 함유된 항암물질이 암 종양을 둘러싸고 있는 종양 세포외 기질을 통과하지 못해 항암치료의 효율성이 낮다는 단점과 함께 항암제 투여 시 암세포 간 압력에 의해 항암제가 종양 안쪽까지 전달되지 못한다는 한계가 있습니다.
□ 이에 연구팀은 종양 세포외 기질을 분해할 수 있는 효소를 함유한 약독화 살모넬라균을 개발하였습니다.
ㅇ 박테리아가 암을 표적화하면 종양 세포외 기질의 주요성분인 히알루론산을 분해할 수 있는 히알루로니다아제 효소를 종양세포에 분비하여 세포외 기질의 경계를 허물어 약물 침투성이 높아져 항암물질이 종양 내부까지 침투할 수 있어 항암치료의 효과를 높일 수 있다는 것입니다.
ㅇ 연구팀은 췌장암과 유방암에 걸린 마우스 동물모델 실험을 통해 개발한 살모넬라균이 암세포의 성장 억제와 사멸이 진행되었으며 면역반응이 나타남을 확인하였습니다.
□ 연구책임자인 박승환 박사는 “암 탐지 및 표적 박테리아에 종양 세포외 기질 분해 효소를 발현시켜 종양 조직의 와해를 유도함으로써 지금까지 한계로 꼽혀온 종양 조직 약물 침투성과 방사선 치료침투 한도 등을 극복해 항암 복합치료제로서의 사용 가능성이 기대된다.”라며,
ㅇ “이번 연구를 통해 개발된 엔지니어링 박테리아는 효과적인 암 탐지 및 표적, 항암물질과 같은 다양한 치료물질의 효율적인 전달체로 항암치료 효과를 증대시킬 것이며, 이번 연구를 기반으로 한국인 마이크로바이옴 뱅크에서 우수한 항암 표적 박테리아를 발굴하여 마이크로바이옴 기반 항암 생균치료제 개발에 기여하겠다.”라고 밝혔습니다.
□ 한편 이번 연구는 약물전달시스템 분야의 세계적인 저널인 Journal of Controlled Release(IF 11.467) 3월호의 표지 논문으로 선정되었으며,
(논문명 : ECM-targeting bacteria enhance chemotherapeutic drug efficacy by lowering IFP in tumor mouse models/ 교신저자 : 박승환 박사 / 제1저자 : 김지선 박사)
ㅇ 과기정통부 바이오‧의료기술개발사업, 생명연 주요사업, 산업부 산업핵심기술개발 사업의 지원으로 수행되었습니다.
Open Access@KRIBB: Park, Seung Hwan (박승환)
- 최근 10년 논문의 KRIBB 공동연구자 (주저자 논문 20편 이상인 저자는 주저자 논문만을 대상)
oak.kribb.re.kr

그림1. Journal of Controlled Release지 표지 선정(355권, 2023.3.)
종양 세포외 기질 분해 효소를 함유한 약독화 살모넬라균의 암 탐지 및 표적 치료 모식도
그림2. 히알루로니다아제(HAase) 활성 측정
a) 형질전환된 세균(SLHAase 또는 SLlux/HAase)에서 L-아라비노스에 의해 히알루로니다아제의 발현이 유도되어
히알루론산(HA)를 분해함을 HA plate에서 clear zone 생성과 IVIS 이미지로 확인함
b) 조작된 박테리아의 HAase 활성의 정량 분석

그림 3. 히알루로니다아제(HAase) 발현 박테리아에 의한 생체 내 히알루론산(HA) 분해
L-아라비노스에 의해 SLlux/HAase에서 HAase의 발현이 유도되어 종양 세포외 기질의 HA이 분해됨을 확인

그림 4. 유방암 마우스 모델(4T1)과 췌장암 마우스 모델(ASPC-1)의 종양 조직에서
종양 세포외 기질 분해 효소 함유한 치료제에 의한 종양 간 유체 압력(IFP)의 변화
HAase 발현 박테리아(SLlux/HAase)에 의해 4T1과 ASPC-1 종양 마우스의 종양 내 IFP가 크게 감소됨을 확인

그림 5. 유방암 마우스 모델(4T1)에서 종양 세포외 기질 분해 효소 함유한 치료제의 향상된 항암치료 효과 확인
4T1 종양 마우스에서 HAase 발현 박테리아(SLlux/HAase)와 항생물질인 독소루비신을 함께 주입했을 때 종양 억제 효과가 증대됨

그림 6. 췌장암 마우스 모델(ASPC-1)에서 종양 세포외 기질 분해 효소 함유한 치료제의 향상된 항암치료 효과 확인
ASPC-1 종양 마우스에서 HAase 발현 박테리아(SLlux/HAase)와 항생물질인 독소루비신을 함께 주입했을 때 종양 억제 효과의 증대됨

그림 7. 췌장암 마우스 모델(ASPC-1)에서 종양 세포외 기질 분해 효소(SLlux/HAase)에 의한 종양억제 효과 메커니즘
HAase 발현 박테리아(SLlux/HAase)는 CD44의 발현을 감소시켜 HA와 CD44의 결합을 억제하여 종양세포의 증식(Ki-67)과 세포사멸(TUNEL)을 유도함. HAase 발현 박테리아(SLlux/HAase)와 항생물질인 독소루비신을 함께 처리하였을 때 그 효과는 증대됨
'생명공학' 카테고리의 다른 글
| mRNA 항체 발굴 -항암 항체 소개 (1) | 2023.11.30 |
|---|---|
| 한국생명공학연구원_ (0) | 2023.11.29 |
| 단백질 (0) | 2023.11.24 |
| 유전자와 질병 (0) | 2023.11.24 |
| 화학물질 및 생물검정 (0) | 2023.11.23 |
